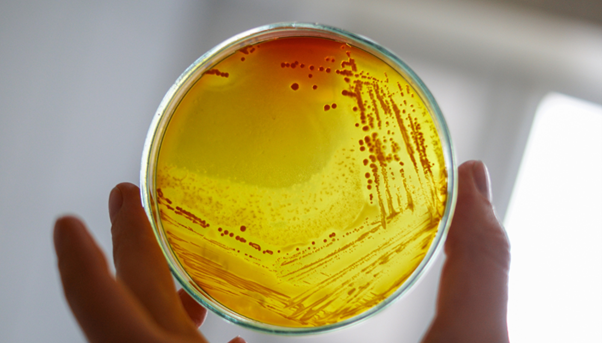

Antimicrobial resistance (AMR) is a daunting global health problem. It is a particular challenge for infections associated with biofilms, where bacteria grow inside protein-carbohydrate matrices and proliferate on wounds and implanted medical devices. Biofilms make infections difficult to treat as conventional antimicrobials struggle to penetrate the film, reducing their effectiveness.
AMR may be tackled by treatments with a novel mode of action, such as antimicrobial photodynamic therapy (aPDT) where light is used to remotely kill microbial cells. Under light irradiation, a photosensitiser is excited to a triplet state where it reacts with molecular oxygen to produce reactive oxygen species (ROS) and singlet oxygen (1O2). These species are cytotoxic and are used to kill target cells.
We highlight work from researchers at Dublin City University published in Biomacromolecules.1 The authors synthesised a novel photosensitiser based on zinc tetraphenylporphyrin (ZnTPP), which was coupled to a biocompatible Jeffamine polymer (Jeff-ZnTPP, Figure 1).

Figure 1: Molecular structure of Jeff-ZnTPP, where m ≈ 39, (l + n ≈ 6). Reprinted with permission from L. Tabrizi, et al.1
To evaluate the performance of this system as a potential aPDT agent, the photoluminescence (PL) spectra, lifetime, and triplet excited states were determined using an Edinburgh Instruments’ FLS1000 Photoluminescence Spectrometer and a LP980 Transient Absorption (ns-TA) Spectrometer.
Jeff-ZnTPP and ZnTPP were dissolved in tetrahydrofuran (THF) degassed under a nitrogen environment prior to optical measurements to minimise quenching of triplet excited states. The photophysical properties of the samples were characterised using absorbance, PL, and ns-TA spectroscopies.
Absorbance spectroscopy revealed Jeff-ZnTPP exhibited a maximum absorbance band at 424 nm with lesser bands at 403, 555, and 595 nm (Figure 2, black), which are typical of porphyrin-based compounds.
Next, PL measurements of Jeff-ZnTPP were performed on an FLS1000 to further understand its photophysical properties. Spectral measurements were performed under excitation from the Xenon lamp, with Jeff-ZnTPP exhibiting an emission maximum at ~655 nm and a less intense peak at ~600 nm (Figure 2, red).
The PL lifetime at 655 nm was then studied using the FLS1000 equipped with TCSPC electronics. Under excitation from an Edinburgh Instruments pulsed EPL-375 laser (375 nm), Jeff-ZnTPP exhibited a mono-exponential decay with a lifetime of 1.88 ns (Figure 2, inset). The short nanosecond-range of this lifetime shows it arose from a singlet excited state. However, for its application as an aPDT agent, Jeff-ZnTPP needed to possess a long-lifetime triplet excited state. These PL measurements showed that if the sample did possess a triplet excited state, then it was non-radiative. As such, ns-TA measurements were required as this technique is able to detect non-radiative excited states that exist on microsecond timescales.

Figure 2: Normalised absorbance (black) and PL emission (red) spectra for Jeff-ZnTPP. Inset: TCSPC fluorescence decay, fitting, and lifetime of Jeff-ZnTPP. Reprinted with permission from L. Tabrizi, et al.1
Next, ns-TA measurements were performed using an Edinburgh Instruments LP980 equipped with a Q-switched Nd:YAG laser operating at 355 nm as the pump source and the Xe lamp as the probe. These measurements would determine if Jeff-ZnTPP possessed a triplet state and determine its lifetime; these are critical parameters for PDT agents, as triplet excited states are required for the generation of ROS and 1O2. The longer the triplet lifetime, the greater the production of the species which kill the target cells. The LP980 is unique in that it is the only ns-TA spectrometer on the market that is capable of both spectral and kinetic measurements, making it an ideal tool for characterisation of PDT agents.
Jeff-ZnTPP exhibited a main ground state bleach at 425 nm, with smaller bands at 550 and 590 nm (Figure 3a) corresponding to bands observed in the absorbance spectrum.
Focusing on the band at 550 nm, the decay of Jeff-ZnTPP was found to possess two components with lifetimes τ1 = 12.94 μs and τ2 = 72.26 µs (Figure 3b). These microsecond lifetimes show that the sample is able to undergo intersystem crossing to a triplet excited state. The average triplet lifetime of Jeff-ZnTPP was also significantly longer than the lifetime of Zn-TPP alone (72 µs vs 30 µs, respectively). This difference was attributed to the effect of the polymer which surrounds the photosensitiser, shielding it from solvent quenching processes, therefore improving its performance as an aPDT agent.

Figure 3: (a) Jeff-ZnTPP ns-TA spectrum and (b) decay and fit at 550 nm. Reprinted with permission from L. Tabrizi, et al.1
This Research Highlight has shown how the FLS1000 and LP980 can be used to determine crucial parameters of PDT agents such as PL spectra, PL lifetime, and triplet state lifetimes. The dual-capability of spectral and lifetime measurements on the LP980 makes characterisation of triplet states easy, and is highly suited to researchers making novel PDT agents.
The authors showed how conjugation of ZnTPP to a Jeffamine polymer improved the triplet lifetimes, thus increasing its efficacy as an aPDT agent. Results like these provide a strong basis for the development of new aPDT agents to tackle the growing problem of AMR and biofilms.
The article was published in Biomacromolecules and is available at:
https://doi.org/10.1021/acs.biomac.4c01011